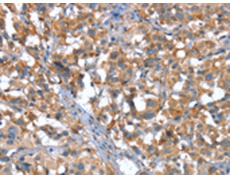
一抗

英文名稱(chēng): Anti-CACNA1G rabbit polyclonal antibody
別 名: NBR13; Cav3.1; Ca(V)T.1
儲(chǔ) 存: 冷凍(-20℃)
宿 主: Rabbit
抗 原: CACNA1G
反應(yīng)種屬: Human, Rat
標(biāo) 記 物: Unconjugate
克隆類(lèi)型: rabbit polyclonal
技術(shù)規(guī)格
|
Background: |
Voltage-dependent calcium channels mediate the entry of calcium ions into excitable cells, and are also involved in a variety of calcium-dependent processes, including muscle contraction, hormone or neurotransmitter release, and gene expression. Calcium channels are multisubunit complexes composed of alpha-1, beta, alpha-2/delta, and gamma subunits. The channel activity is directed by the pore-forming alpha-1 subunit, whereas, the others act as auxiliary subunits regulating this activity. The distinctive properties of the calcium channel types are related primarily to the expression of a variety of alpha-1 isoforms, alpha-1A, B, C, D, E, and S. This gene encodes the alpha-1A subunit, which is predominantly expressed in neuronal tissue. Mutations in this gene are associated with 2 neurologic disorders, familial hemiplegic migraine and episodic ataxia 2. |
|
Applications: |
ELISA, IHC |
|
Name of antibody: |
CACNA1G |
|
Immunogen: |
Synthetic peptide of human CACNA1G |
|
Full name: |
calcium channel, voltage-dependent, T type, alpha 1G subunit |
|
Synonyms: |
NBR13; Cav3.1; Ca(V)T.1 |
|
SwissProt: |
O43497 |
|
ELISA Recommended dilution: |
1000-2000 |
|
IHC positive control: |
Human thyroid cancer and Human liver cancer |
|
IHC Recommend dilution: |
15-50 |

 購(gòu)物車(chē)
購(gòu)物車(chē) 幫助
幫助
 021-54845833/15800441009
021-54845833/15800441009